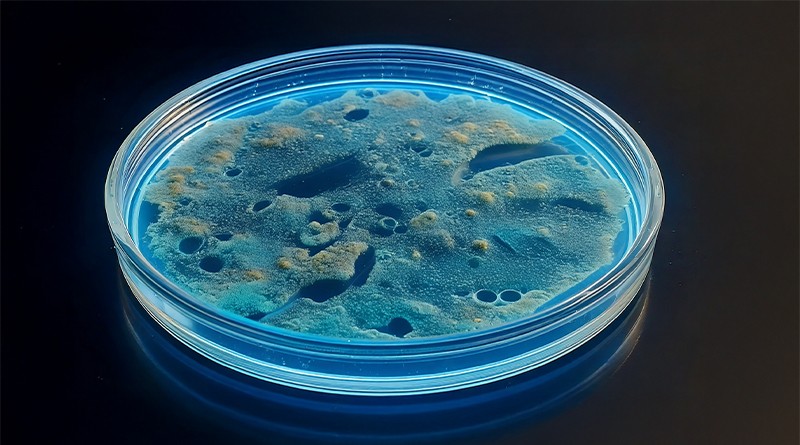

- Food & Consumer Goods
Microbiology testing
Accurate, reliable, comprehensive.
Ensure food safety with expert microbiology testing
We understand the critical importance of microbiological safety in the food and consumer goods industry. Our comprehensive microbiology testing services are designed to detect and quantify microorganisms that can affect product quality and consumer health. Utilizing state-of-the-art technology and adhering to stringent industry standards, we provide precise and reliable results to ensure your products meet safety regulations and maintain consumer trust.
Overview of our services
- Pathogen detection (e.g., Salmonella, Listeria, E. coli)
- Spoilage organism analysis
- Environmental monitoring
- Shelf-life studies
- Hygiene audits
- ISO 17025 accredited laboratory
Our Experts:

Your partner for precise analyses and independent assessments.
Learn more

Expertise in analysis to ensure quality and safety.
Learn more

Your partner for comprehensive safety and hygiene solutions with over 45 years of experience.
Learn more

DIN EN ISO/IEC 17025:2018
Comprehensive analysis and hygiene solutions for safer environments.
Learn more

Triskelion offers precise analytics and comprehensive safety assessments.
Learn more
The industries:
- Pharma
- Medical devices
- Scientific community
- Food / agri Producers
- Consumer goods producer
- Chemical
- Food retail
- Catering / food distribution
- CRO